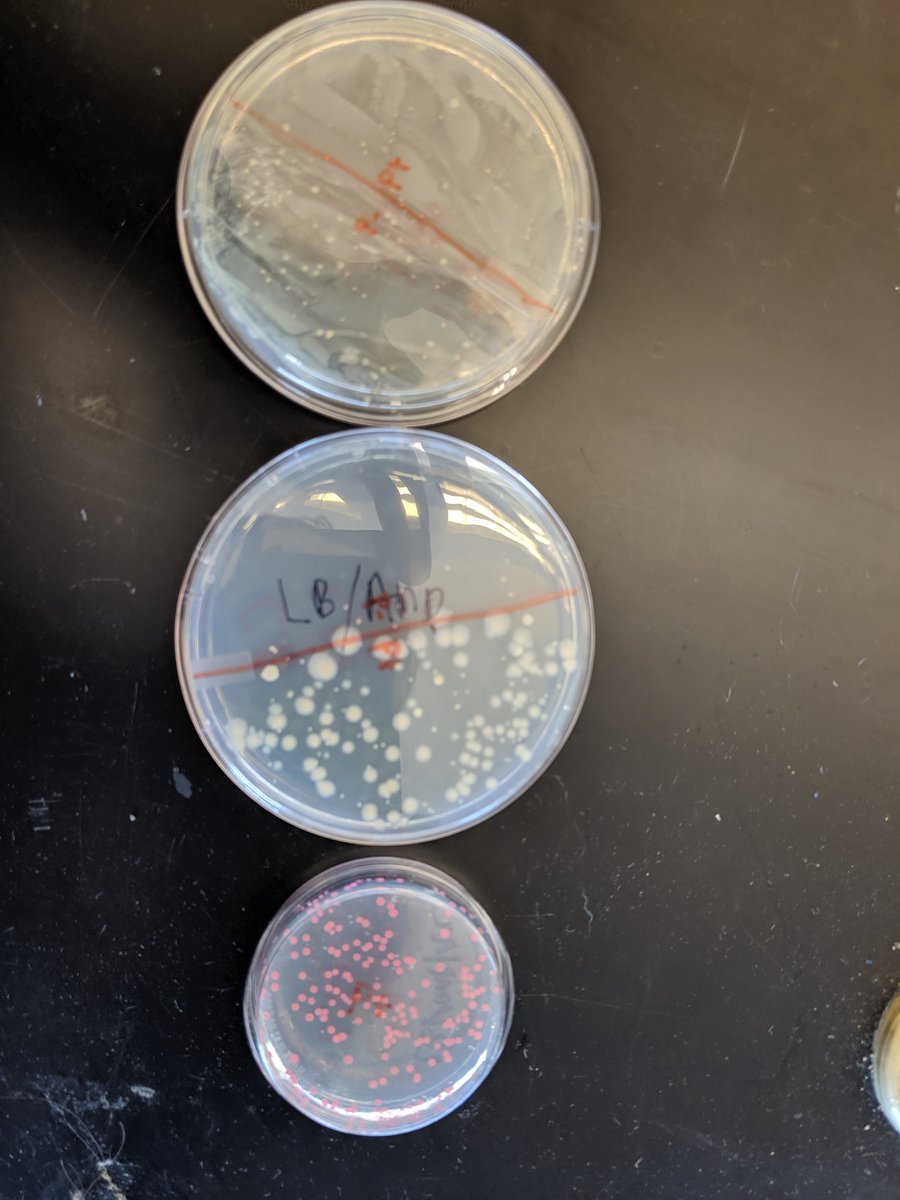
Students had amazing bacterial transformation results! Big shout out to @aliaqatarneh and <a href="/ABEProgOffice/">Amgen Biotech Experience (ABE) Program Office</a> for allowing students to see the joy of biotechnology! #RFP #biotech

Mr. Lepak
@bradlepak
East Boston High School AP Biology, Biotechnology, and Chemistry Teacher. Science and video game nerd. He/Him.
ID: 1174644068401524736
19-09-2019 11:19:15
29 Tweet
62 Followers
69 Following

Students had amazing bacterial transformation results! Big shout out to @aliaqatarneh and Amgen Biotech Experience (ABE) Program Office for allowing students to see the joy of biotechnology! #RFP #biotech

AP Biology had a wonderful time modeling cell membranes with bubbles! Who says science can't be fun and creative? EBHS Science #bubbletime #scienceiscool



Students had a great time at the museum of science for chemistry week! Thank you Museum of Science for the wonderful experience! EBHS Science


What could be better than a BostonPublicSchools Teacher Gathering at Vertex Pharmaceuticals during #MassSTEMWeek?! Played with #CRISPR..look at that gel! So grateful for Melodie Knowlton and Amandadillingham for their leadership in all this work!


And just like that STEM WEEK Science at Lunch is over! Love East Boston High students! You can see us tomorrow at the BPS STEM EXPO tomorrow! See you there! BostonPublicSchools


Just finished an amazing transformation lab from Systems Sally ! Students had a great experience learning about chassis selection and synthetic biology. EBHS Science


East Boston High BostonPublicSchools and Essex North Shore Agricultural & Technical School Biotech Pathway students partner to determine Patient Zero after the Zombie virus outbreak!


Great way to spend a Saturday morning! Students hard at work studying for the AP biology exam! Thank you Mass Insight! EBHS Science


Congratulations to our award recipients from the 74th Boston science fair from Eastie! EBHS Science East Boston High


Labs at home! Thank you to Mass Insight miniPCR bio Massachusetts Life Sciences Center for helping my students get hands on experience in biotechnology skills and interesting labs in these tough times!


We East Boston High are so proud to accept the 2019/2020 Joshua Boger Innovative School of the Year award from @MassBioEd! We will be there in force on Nov. 18th 6-7! #Champs4BioEd. bit.ly/2STqrZY. Mr. Faiz Mr. Lepak Denise Puopolo Andre Williams Amandadillingham

Had a great time planning engineering mentoring with CELL-MET and Amandadillingham! My students are ready to teach how important and interesting engineering is to younger students! EBHS Science


Excited to pack take home kits so my AP students can do BioBits® at home! Thank you Mass Insight for helping provide this opportunity! miniPCR bio EBHS Science


AP bio students loved doing BioBits® at home! Thank you Mass Insight and Massachusetts Life Sciences Center for this amazing opportunity for hands on learning in this difficult time. EBHS Science


Tonight at 6! Tune into WBZ-TV Boston to hear about Mass Insight's Science from Home program in partnership with Massachusetts Life Sciences Center, miniPCR bio, and PTC, bringing lab kits to Boston AP Bio students! Massachusetts K-12 WBZ | CBS News Boston PAULA EBBEN

My students never cease to amaze me! Students worked on modeling cellular respiration in the cell and then gave constructive feedback to each other. I love how every group created a different model even though they all had the same references. EBHS Science


Having a blast at NSTA! Thanks you Vertex Pharmaceuticals for sponsoring our growth as teachers. Denise Puopolo

